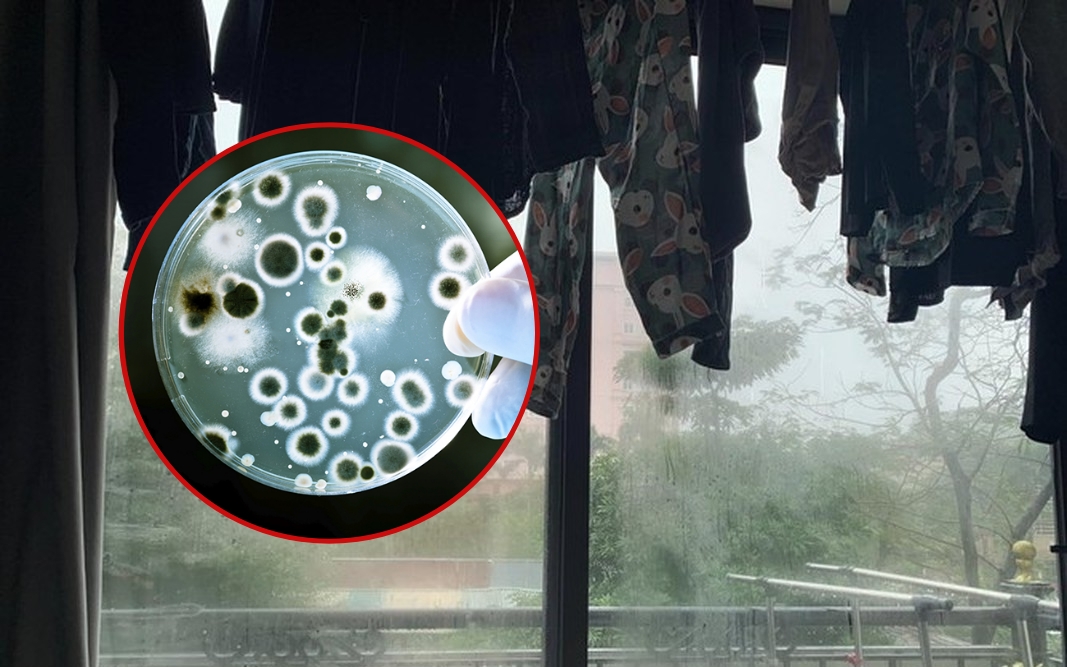

Công nghệ
Apple chính thức khai tử iPhone màn hình nhỏ
iPhone nhỏ nhất giờ đây có kích thước là 6.1 inch. Với việc ngừng bán iPhone SE, Apple đã chính thức khai tử dòng iPhone màn hình nhỏ, khi không còn mẫu smartphone nào...
Tin tức
Bác sĩ: Nếu đang phơi quần áo trong nhà, nên dừng lại ngay!
Chuyên gia cảnh báo rằng, thói quen này có thể ảnh hưởng đến sức khỏe con người, làm suy giảm khả năng miễn dịch, thậm chí gia tăng nguy cơ ung thư và gây...
Tin tức
Facebook có thay đổi quan trọng, người dùng cần biết
Một thay đổi bất ngờ từ Facebook có thể khiến nhiều người dùng đứng ngồi không yên về những nội dung video yêu thích của mình. Facebook vừa đưa ra một thay đổi bất...